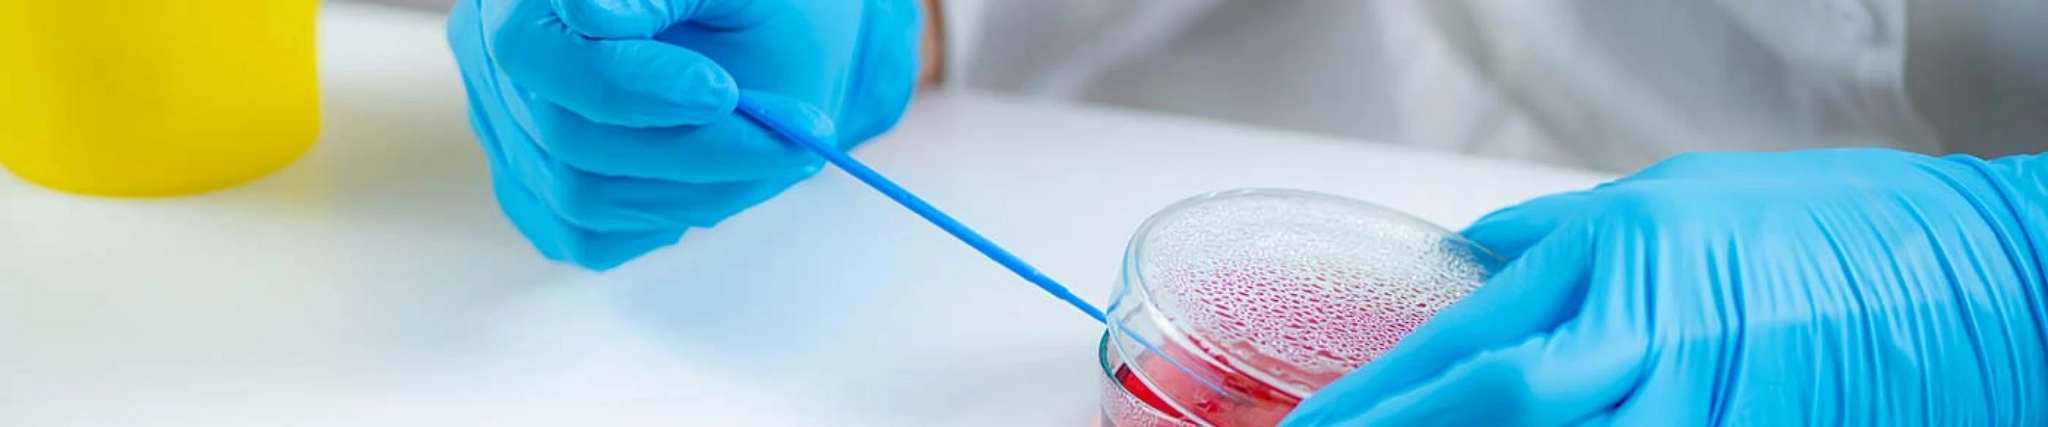
Your guide to know everything you need about studying Biomedical Science

Your guide to know everything you need about studying Biomedical Science
What you need to know about Biomedical Science
Biomedical Sciences: What Is It?
Understanding the workings of the human body's systems, organs, and cells is the main goal of a degree in biomedical sciences. The curriculum includes topics like immunology, microbiology, and genetics, all of which are crucial to comprehending and treating illnesses.
Specializations in Biomedical Sciences
Medical microbiology, clinical biochemistry, haematology, and immunology are the most prevalent areas of specialization in the biomedical sciences, as they are in most other sciences today.
Considering the complexity of the topic, becoming an expert in any of the aforementioned fields often requires at least a Master's degree.
In a program in biomedical sciences, what will you learn?
Studying biochemical and physiological processes, anatomical and histological structures, epidemiology, and pharmacology are all part of a biomedical science degree. Learn the fundamentals of nutrition, illness, and immunology to both maintain and enhance health in humans and animals.
Enrolling in a Biomedical Sciences program equips you with comprehensive understanding of human anatomy and biology, histology—the microscopic examination of biological and anatomical tissues—epidemiology—the study of how health and disease are determined, and pharmacology. You'll discover the following in greater detail:
comprehensive knowledge of human anatomy and physiology; comprehension of the cellular and molecular causes of diseases; abilities to conduct laboratory tests and analyze the results; expertise in disease monitoring and diagnosis; and knowledge of the role that genetics plays in health and disease.
Among the courses you'll probably take are:
Studying the human body and its activities is done in human anatomy and physiology;
Studying the cellular and molecular processes that support life is known as cellular and molecular biology.
pathophysiology, which studies the functional alterations brought on by illness;
Immunology is the study of the immune system and how it functions in both health and illness.
Medical genetics is the study of how genes affect health and disease.
A degree in biomedical sciences is thrilling and demanding. If you're interested in health, illness, and the science that underpins medicine but aren't interested in becoming a doctor, this is a great option for you. Courses in biomedical sciences can help you advance your career in a variety of health-related fields, such as clinical diagnostics, public health, and research.
Qualifications needed for a Biomedical Sciences degree
Proficiency in biology and chemistry, aptitude for precise and rigorous work, and strong analytical and problem-solving abilities are all prerequisites for a degree in biomedical sciences. Practical laboratory abilities are also essential, as laboratory testing constitutes a significant portion of the work.
Biomedical Science Careers
- Biomedical Scientist
- Clinical Laboratory Scientist
- Research Scientist
- Genetic Counsellor
- Healthcare Scientist